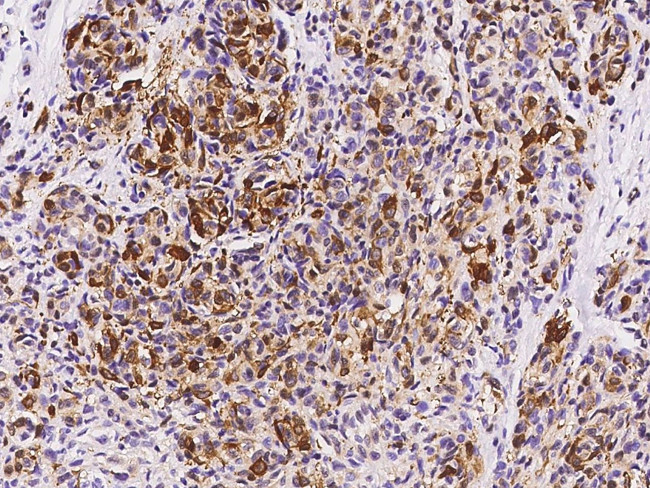
FABP7 Antibody in Immunohistochemistry (Paraffin) (IHC (P))

Search
Invitrogen
FABP7 Polyclonal Antibody
{{$productOrderCtrl.translations['antibody.pdp.commerceCard.promotion.promotions']}}
{{$productOrderCtrl.translations['antibody.pdp.commerceCard.promotion.viewpromo']}}
{{$productOrderCtrl.translations['antibody.pdp.commerceCard.promotion.promocode']}}: {{promo.promoCode}} {{promo.promoTitle}} {{promo.promoDescription}}. {{$productOrderCtrl.translations['antibody.pdp.commerceCard.promotion.learnmore']}}








Please note: We are reviewing Western blot images included in the antibody testing data in our catalog, including those provided by third parties. Unless expressly labeled or annotated as “raw-unedited”, Western blot images included in the antibody testing data in our catalog may have been edited, optimized or otherwise adjusted for presentation.
产品信息
PA5-117944
种属反应
宿主/亚型
分类
类型
抗原
偶联物
形式
纯化类型
保存液
内含物
保存条件
运输条件
RRID
靶标信息
FABP7 was initially isolated from a human fetal brain cDNA library and whose mRNA was expressed in adult brain and muscle tissues at low levels. The protein encoded by this gene is a member of the fatty acid binding protein (FABPs) family, a group of small, highly conserved, cytoplasmic proteins that bind long-chain fatty acids and other hydrophobic ligands. FABPs are thought to play roles in fatty acid uptake, transport, and metabolism. FABP7 is a downstream gene of the Pax6 transcription factor and has been suggested to be essential for the maintenance of neuroepithelial cells during early cortical development. More recently, FABP7 was found to be frequently expressed in melanomas. Down-regulation of FABP7 through RNAi expression could reduce in vitro cell proliferation and Matrigel invasion, suggesting that FABP7 may be a potential target for the development of diagnostic and therapeutic tools.
仅用于科研。不用于诊断过程。未经明确授权不得转售。
篇参考文献 (0)
生物信息学
蛋白别名: B FABP; B-FABP; BLBP; Brain lipid-binding protein; Brain-type fatty acid-binding protein; DKFZp547J2313; FABP 7; Fatty acid-binding protein 7; Fatty acid-binding protein, brain; Mammary-derived growth inhibitor related; OTTHUMP00000017119; RP11-548E19.1
基因别名: BLBP; FABP7; FABPB; MRG
Entrez Gene ID: (Human) 2173